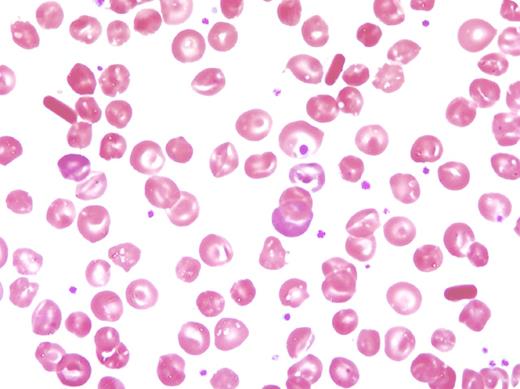
A 44-year-old African American female presented with a pain crisis and a history of hemoglobinopathy, menometrorrhagia secondary to acquired von Willebrand factor (vWF) deficiency, and a history of multiple vaso-occlusive events necessitating lifelong warfarin therapy. Further history revealed that she had four pain crises in the previous year requiring hospitalizations, multiple splenic infarcts with resultant autosplenectomy, one normal pregnancy with no preceding miscarriages, and no history of bone necrosis. Current symptoms include sternal pain, mild diffuse abdominal pain, and bilateral hip and knee pain causing difficulty with ambulation. Physical examination showed normal vital signs and cardiopulmonary function, nonpalpable liver and spleen, and pain with decreased range of motion of bilateral hip and knee joints. Complete blood count revealed a white blood cell count of 10.9 × 103/µL with normal differential, hemoglobin of 12.1 g/dL, platelet count of 794 × 103/µL, and reticulocyte count of 4.1%. Testing for the vWF revealed vWF antigen of 80%, vWF activity of 39%, and factor VIII activity of 120%. Peripheral blood smear showed microspherocytes, target cells, and hemoglobin crystals. Hemoglobin electrophoresis confirmed homozygous hemoglobin C. Upon admission to the hospital, she was started on intravenous fluids and pain medications, and her symptoms improved. / Although rare, vaso-occlusive events and acquired vWF deficiency have been reported in patients with nonhemoglobin S hemoglobinopathies. In patients with a peripheral blood smear showing microspherocytes, target cells, and hemoglobin crystals, homozygous hemoglobin C disease should be suspected.

A 44-year-old African American female presented with a pain crisis and a history of hemoglobinopathy, menometrorrhagia secondary to acquired von Willebrand factor (vWF) deficiency, and a history of multiple vaso-occlusive events necessitating lifelong warfarin therapy. Further history revealed that she had four pain crises in the previous year requiring hospitalizations, multiple splenic infarcts with resultant autosplenectomy, one normal pregnancy with no preceding miscarriages, and no history of bone necrosis. Current symptoms include sternal pain, mild diffuse abdominal pain, and bilateral hip and knee pain causing difficulty with ambulation. Physical examination showed normal vital signs and cardiopulmonary function, nonpalpable liver and spleen, and pain with decreased range of motion of bilateral hip and knee joints. Complete blood count revealed a white blood cell count of 10.9 × 103/µL with normal differential, hemoglobin of 12.1 g/dL, platelet count of 794 × 103/µL, and reticulocyte count of 4.1%. Testing for the vWF revealed vWF antigen of 80%, vWF activity of 39%, and factor VIII activity of 120%. Peripheral blood smear showed microspherocytes, target cells, and hemoglobin crystals. Hemoglobin electrophoresis confirmed homozygous hemoglobin C. Upon admission to the hospital, she was started on intravenous fluids and pain medications, and her symptoms improved.
Although rare, vaso-occlusive events and acquired vWF deficiency have been reported in patients with nonhemoglobin S hemoglobinopathies. In patients with a peripheral blood smear showing microspherocytes, target cells, and hemoglobin crystals, homozygous hemoglobin C disease should be suspected.
A 44-year-old African American female presented with a pain crisis and a history of hemoglobinopathy, menometrorrhagia secondary to acquired von Willebrand factor (vWF) deficiency, and a history of multiple vaso-occlusive events necessitating lifelong warfarin therapy. Further history revealed that she had four pain crises in the previous year requiring hospitalizations, multiple splenic infarcts with resultant autosplenectomy, one normal pregnancy with no preceding miscarriages, and no history of bone necrosis. Current symptoms include sternal pain, mild diffuse abdominal pain, and bilateral hip and knee pain causing difficulty with ambulation. Physical examination showed normal vital signs and cardiopulmonary function, nonpalpable liver and spleen, and pain with decreased range of motion of bilateral hip and knee joints. Complete blood count revealed a white blood cell count of 10.9 × 103/µL with normal differential, hemoglobin of 12.1 g/dL, platelet count of 794 × 103/µL, and reticulocyte count of 4.1%. Testing for the vWF revealed vWF antigen of 80%, vWF activity of 39%, and factor VIII activity of 120%. Peripheral blood smear showed microspherocytes, target cells, and hemoglobin crystals. Hemoglobin electrophoresis confirmed homozygous hemoglobin C. Upon admission to the hospital, she was started on intravenous fluids and pain medications, and her symptoms improved.
Although rare, vaso-occlusive events and acquired vWF deficiency have been reported in patients with nonhemoglobin S hemoglobinopathies. In patients with a peripheral blood smear showing microspherocytes, target cells, and hemoglobin crystals, homozygous hemoglobin C disease should be suspected.
For additional images, visit the ASH IMAGE BANK, a reference and teaching tool that is continually updated with new atlas and case study images. For more information visit http://imagebank.hematology.org.

This feature is available to Subscribers Only
Sign In or Create an Account Close Modal